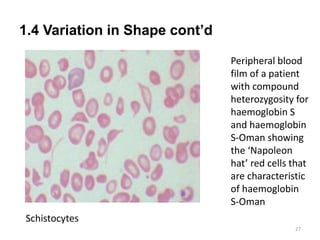
1.4 Variation in Shape cont’d
27
Schistocytes
Peripheral blood
film of a patient
with compound
heterozygosity for
haemoglobin S
and haemoglobin
S-Oman showing
the ‘Napoleon
hat’ red cells that
are characteristic
of haemoglobin
S-Oman
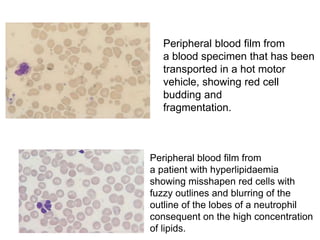
Peripheral blood film from
a blood specimen that has been
transported in a hot motor
vehicle, showing red cell
budding and
fragmentation.
Peripheral blood film from
a patient with hyperlipidaemia
showing misshapen red cells with
fuzzy outlines and blurring of the
outline of the lobes of a neutrophil
consequent on the high concentration
of lipids.
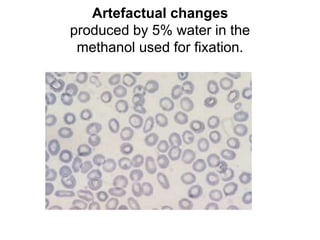
Artefactual changes
produced by 5% water in the
methanol used for fixation.
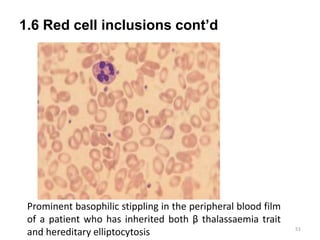
1.6 Red cell inclusions cont’d
51
Prominent basophilic stippling in the peripheral blood film
of a patient who has inherited both β thalassaemia trait
and hereditary elliptocytosis
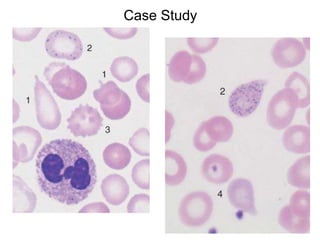
Case Study
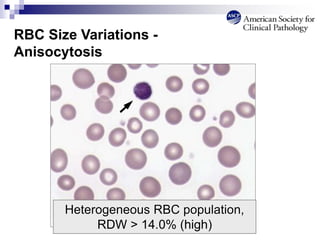
RBC Size Variations -
Anisocytosis
Heterogeneous RBC population,
RDW > 14.0% (high)
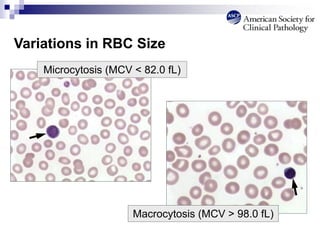
Variations in RBC Size
Microcytosis (MCV < 82.0 fL)
Macrocytosis (MCV > 98.0 fL)
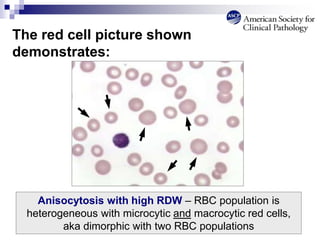
The red cell picture shown
demonstrates:
Anisocytosis with high RDW – RBC population is
heterogeneous with microcytic and macrocytic red cells,
aka dimorphic with two RBC populations
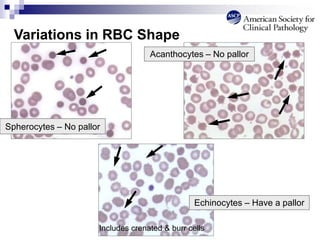
Spherocytes – No pallor
Acanthocytes – No pallor
Variations in RBC Shape
Echinocytes – Have a pallor
Includes crenated & burr cells
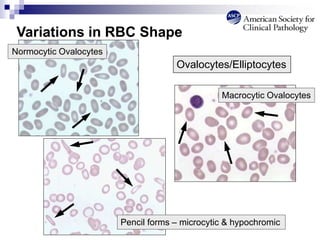
Variations in RBC Shape
Pencil forms – microcytic & hypochromic
Ovalocytes/Elliptocytes
Normocytic Ovalocytes
Macrocytic Ovalocytes
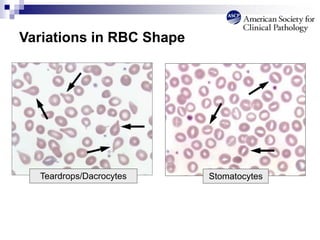
Variations in RBC Shape
Stomatocytes
Teardrops/Dacrocytes
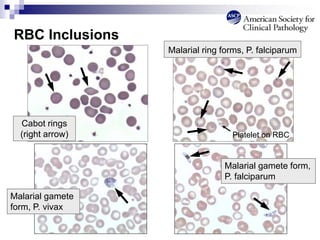
RBC Inclusions
Malarial gamete
form, P. vivax
Malarial gamete form,
P. falciparum
Malarial ring forms, P. falciparum
Platelet on RBC
Cabot rings
(right arrow)
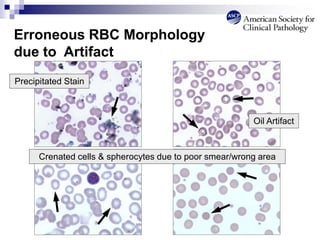
Erroneous RBC Morphology
due to Artifact
Oil Artifact
Precipitated Stain
Crenated cells & spherocytes due to poor smear/wrong area

This document provides an overview of red blood cell morphology assessment. It discusses the morphology of normal red blood cells and various abnormal red blood cell forms including variations in size, shape, hemoglobinization, and distribution. Examples of different abnormalities such as macrocytosis, microcytosis, elliptocytes, schistocytes, and rouleaux formation are described. The purpose is to enable students to identify red blood cell abnormalities and correlate them with underlying clinical conditions by examining stained blood films under a microscope.